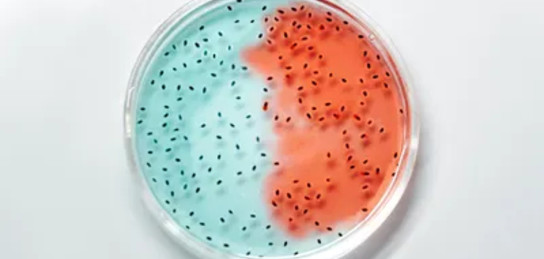

Ученые выявили связь особого сахара с повреждением клеток мозга
© Фото: pexels
Кишечные бактерии способны выделять особый сахар, повреждающий клетки мозга. К такому выводу пришли иностранные ученые, сообщает Zakon.kz.
Кишечные бактерии могут вырабатывать нестандартную форму сахара, которая запускает иммунное воспаление и повреждает клетки мозга. Об этом заявили ученые из американского университета Case Western Reserve. Их научная работа опубликована в издании Earth.
Речь идет о бактериальном гликогене, который производят некоторые микробы кишечника. Исследование показало, такие сахара активируют иммунные клетки, вызывая выброс цитокинов – молекул, распространяющих воспаление по всему организму, включая мозг.
Особенно опасным этот механизм оказался для людей с мутацией гена C9ORF72 – одной из главных наследственных причин склероза и лобно-височной деменции. Когда ослабевает очистительная функция гена, иммунные клетки теряют способность удалять бактериальные сахариды.
По экспериментам на мышах ученые поняли, что один из видов кишечных бактерий может разрушать гематоэнцефалический барьер – защиту мозга – и способствовать проникновению иммунных клеток в нервную ткань. Это сопровождается повреждением нейронов.
"Интересно, что не все формы бактериального сахара одинаково вредны: наиболее опасными оказались плотные, сложно устроенные молекулы, которые труднее расщепляются и дольше поддерживают воспаление", – отметили авторы статьи.
Попытка нейтрализовать эффект дала лишь частичный результат. Когда животным давали фермент альфа-амилазу, расщепляющий такие сахара, уровень воспаления снижался, а состояние мозга улучшалось. Впрочем, это не позволило полностью остановить болезнь.
Анализ образцов у людей продемонстрировал похожий эффект: вредный гликоген обнаружили у большинства пациентов с боковым амиотрофическим склерозом на ранних стадиях заболевания. Это указывает на его возможную роль как раннего биомаркера.
Ученые полагают, что кишечник играет активную роль в развитии нейродегенеративных заболеваний. Однако для подтверждения этого утверждения и разработки лечения нужны более масштабные исследования на людях.
Ранее мы писали, как защитить себя от острых кишечных инфекций.
Источник: zakon.kz
Подписывайтесь на наш Telegram-канал. Будьте в курсе всех событий!
Мы работаем для Вас!
Читайте также:
-
21:39, 21 апреля 2026
Какие купальники будут носить в 2026 году: что станет хитом сезона
-
21:20, 21 апреля 2026
Пропажа на 46 миллионов тенге: как с пастбища исчезли десятки голов скота
-
21:11, 21 апреля 2026
Деньги и любовь «свалятся сами»: кому предсказан успех в 2026 году
-
20:56, 21 апреля 2026
Игра в бассейне закончилась гибелью 12-летней бразильянки
-
20:24, 21 апреля 2026
Суицид или нет: в Актау родители требуют повторного расследования смерти дочери





















